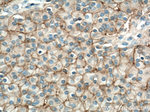
NCAM1/CD56 Antibody in Immunohistochemistry (Paraffin) (IHC (P))
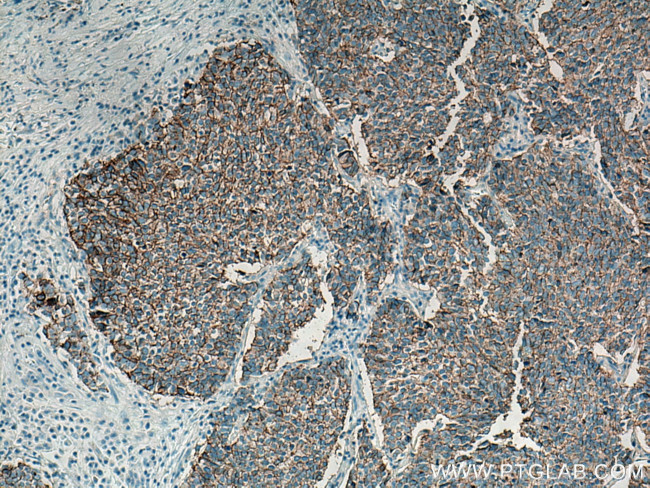
NCAM1/CD56 Antibody in Immunohistochemistry (Paraffin) (IHC (P))

Search
Proteintech
NCAM1/CD56 Polyclonal Antibody
{{$productOrderCtrl.translations['antibody.pdp.commerceCard.promotion.promotions']}}
{{$productOrderCtrl.translations['antibody.pdp.commerceCard.promotion.viewpromo']}}
{{$productOrderCtrl.translations['antibody.pdp.commerceCard.promotion.promocode']}}: {{promo.promoCode}} {{promo.promoTitle}} {{promo.promoDescription}}. {{$productOrderCtrl.translations['antibody.pdp.commerceCard.promotion.learnmore']}}
图: 1 / 19
NCAM1/CD56 Antibody (14255-1-AP) in IHC (P)

产品信息
14255-1-AP
种属反应
已发表种属
宿主/亚型
分类
类型
抗原
偶联物
形式
浓度
规格
纯化类型
保存液
内含物
保存条件
运输条件
产品详细信息
Immunogen sequence: EISVGESKF FLCQVAGDAK DKDISWFSPN GEKLTPNQQR ISVVWNDDSS STLTIYNANI DDAGIYKCVV TGEDGSESEA TVNVKIFQKL MFKNAPTPQE FREGEDAVIV CDVVSSLPPT IIWKHKGRDV ILKKDVRFIV LSNNYLQIRG IKKTDEGTYR CEGRILARGE INFKDIQVIV NVPPTIQARQ NIVNATANLG QSVTLVCDAE GFPEPTMSWT KDGEQIEQEE DDEKYIFSDD SSQLTIKKVD KNDEAEYICI AENKAGEQDA TIHLKVFAKP KITYVENQTA MELEEQVTLT CEASGDPIPS ITWRTSTRNI SSEE (30-352 aa encoded by BC047244)
靶标信息
CD56, also known as neural cell adhesion molecule (NCAM), is a highly glycosylated transmembrane glycoprotein of the immunoglobulin family. It plays a crucial role in cell adhesion, migration, axonal growth, pathfinding, and synaptic plasticity. CD56 is ubiquitously expressed in the nervous system in isoforms ranging from 120-180 kDa and is involved in homotypic adhesion of neural cells. It mediates interactions by binding extracellular matrix components such as laminin and integrins, with polysialic modification reducing CD56-mediated adhesion. In the hematopoietic system, CD56 is expressed on natural killer (NK) cells and a subset of T cells known as NKT cells. It is also found on most neuroectodermal-derived cell lines, tissues, and neoplasms, including retinoblastoma, medulloblastoma, astrocytomas, and neuroblastoma. CD56 serves as a widely used neuroendocrine marker with high sensitivity for neuroendocrine tumors and ovarian granulosa cell tumors. Diseases associated with CD56 dysfunction include rabies and blastic plasmacytoid dendritic cell neoplasms, highlighting its importance in both neural and immune system functions.
仅用于科研。不用于诊断过程。未经明确授权不得转售。
生物信息学
蛋白别名: 145 kda neural cell adhesion molecule; antigen recognized by monoclonal antibody 5.1H11; CD-56; CD56; E NCAM; membrane glycoprotein; N CAM1; N-CAM; N-CAM-1; neural cell adhesion molecule; Neural cell adhesion molecule 1; neural cell adhesion molecule secreted isoform; neural cell adhesion molecule, NCAM; sCD56; sNCAM; soluble CD56; soluble NCAM; unnamed protein product
基因别名: CD56; E-NCAM; MSK39; N-CAM; N-CAM-1; NCAM; NCAM-1; NCAM-C; NCAM1; NCAMC
UniProt ID: (Human) P13591, (Mouse) P13595, (Rat) P13596
Entrez Gene ID: (Human) 4684, (Pig) 100515564, (Mouse) 17967, (Rat) 24586